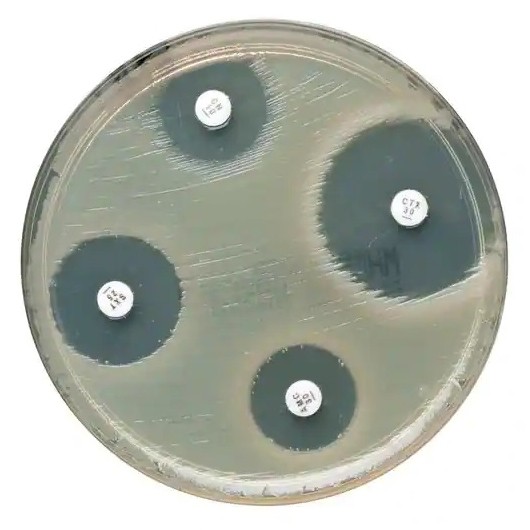
Fosfomycin FOS 200 µg (5x 50 pc., Oxoid)

product description
You might also be interested in the following products
U11 Plus urine test strips (150) comp. with DocUReader 2 PRO
LabStrip U11 Plus is a high-grade, non-bleeding multiparameter urinalysis test...
EUR 14,00 - EUR 19,50
add. 19 % VAT excl. shipping costs
MacConkey/Columbia-CNA biplate agar - 20 pcs.
MacConkey II Agar is a selective differentiation medium for the isolation and...
EUR 13,98 - EUR 14,50
add. 19 % VAT excl. shipping costs
EUR 3,10
add. 19 % VAT excl. shipping costs
MCN Optifit Tip 1200 (Flexi bulk) for Germany, only)
The Optifit pipette tips with a volume of 1200µl are recommended for the use with...
EUR 25,30
add. 19 % VAT excl. shipping costs
8-channel pipettor, 50-1200µl for Germany, only
BIOHIT Picus e-line pipettes have a new ergonomic design, preventing from RSI,...
Price on request
add. 19 % VAT excl. shipping costs
Last viewed
pipet tips 200µl (1000p, bag) Eppendorf-compatible
These 200µl Universal, Bevelled, Loose, Yellow, Non-Sterile tips from Alpha...
EUR 20,92
add. 19 % VAT excl. shipping costs
Ps. aeruginosa ATCC 27853 KWIK STIK (2)
Which reference strains do you need for internal quality control? As a rule,...
EUR 134,00
add. 19 % VAT excl. shipping costs
Bacillus spizizenii ATCC 6633 KWIK STIK (2) - suitable for inhibitor test former S. subtilis
Which reference strains do you need for internal quality control? As a rule,...
EUR 116,00
add. 19 % VAT excl. shipping costs
Bacillus spizizenii ATCC 6633 KWIK STIK (6) - suitable for inhibitor test former S. subtilis
Which reference strains do you need for internal quality control? As a rule,...
EUR 196,00
add. 19 % VAT excl. shipping costs
Customers also purchased
Paddle Pastette drops of 25µl (500 p.)
Two functions: dispensing and mixing Useful for dosing and mixing applications...
EUR 24,99
add. 19 % VAT excl. shipping costs
MCN Optifit Tip 1200 (Flexi bulk) for Germany, only)
The Optifit pipette tips with a volume of 1200µl are recommended for the use with...
EUR 25,30
add. 19 % VAT excl. shipping costs
Kova Liqua-Trol control urines pos and neg c hCG (2x15ml)
Kova Liqua-Trol control urins (positive and normalwith hCG)Â serve as...
EUR 39,50
add. 19 % VAT excl. shipping costs
Kontakt
Bei Rückfragen erreichen Sie unser Kundenbüro telefonisch unter +49 201 21961-701 werktags von 8:00-12:00 und 13:00-17:00 Uhr.
Alternativ schicken Sie uns ein Fax an +49 2573 69795-9917 oder eine E-Mail an service@aurosan.de
Vielen Dank, Ihr Team von AUROSAN.
AUROSAN GmbH | Frankenstr. 231, D-45134 Essen | Tel. +49 201 21961-701 | Fax +49 2573 69795-9917
service@aurosan.de | www.aurosan.de | www.aurosan-shop.de | www.aurosan-gesundes-leben.de








_md1002161_10000.jpg)